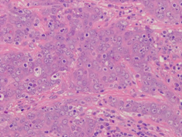
New Picture_0.png

A diagnostic hub for Cancer
In the next instalment of Viapath’s cancer awareness week, we discuss our expert, regional centre for solid cancer diagnostics.
We provide diagnostic cancer services across our four sites at Bedford, Guy’s, King’s and St. Thomas’ Hospitals, with the bulk of this work and specialist testing directed through our regional centres in London.
Using a multidisciplinary approach, comprising; cellular pathology, genetics, molecular oncology and haematology, our services in London operate as regional hubs for London and the South-East, serving populations as far south as Brighton and as far east as Canterbury, as well as receiving specialist referrals from all over the country and internationally.
Here we will discuss our regional centre at Guy’s and St. Thomas’ Hospitals, as well as exploring the diagnosis of solid tumour cancer.
Cancer Specialist Diagnostic Service – a look at solid tumours
Based in the large Regional Genetics Centre at Guy’s Hospital, this fully integrated service builds on our existing expertise in diagnosing haematological malignancies and solid tumours.
As an example, our histopathology laboratory provides comprehensive tissue diagnostics to Guy’s and St. Thomas’, covering a catchment area of approximately 7.5m people across South-East London and South-East England.
Compared with Haematology, Histopathology is considered to be a much more complex and manual process, involving solid tissue samples rather than liquid samples. There are hundreds of different types of solid tumour cancers, making accurate diagnosis imperative to inform appropriate treatment decisions. King’s Health Partners, of which Viapath is a member, covers diagnosis and treatment of almost every known cancer type.
Innovative and collaborative cancer testing
The Consultant Histopathologists at St. Thomas’ Hospital are specialists in fine needle aspiration, which is the process of obtaining a biopsy from a patient in a minimally invasive way, using very thin needles to obtain cells / tissue, rather than having to resort to more invasive techniques like surgery.
Sections of a biopsy are sliced into very thin pieces to be placed into a slide and stained for viewing under the microscope by a consultant. (Pictured right is an example of Metastatic Nasopharyngeal Carcinoma, the lighter cells are cancer and the darker cells are normal).
Sections of a biopsy are sliced into very thin pieces to be placed into a slide and stained for viewing under the microscope by a consultant. (Pictured right is an example of Metastatic Nasopharyngeal Carcinoma, the lighter cells are cancer and the darker cells are normal).
This is the initial phase of investigation in any suspected cancer case, in cases of solid or haematological malignancies and often helps inform further investigation to ascertain the exact type of cancer as well as how far it has progressed and whether or not it has spread beyond the primary tumour.
 In this example, the sample also underwent investigation in immunohistochemistry, using in situ hybridisation to test for Epstein-Barr Virus - an indicator of Nasopharyngeal Carcinoma. In this instance, the diagnosis was confirmed using this technique (pictured left), enabling consultants to create an integrated report, facilitating quicker and more effective treatment decisions for patients.
In this example, the sample also underwent investigation in immunohistochemistry, using in situ hybridisation to test for Epstein-Barr Virus - an indicator of Nasopharyngeal Carcinoma. In this instance, the diagnosis was confirmed using this technique (pictured left), enabling consultants to create an integrated report, facilitating quicker and more effective treatment decisions for patients.
Working with our partners
As part of the London Cancer Alliance, our two host trusts help to shape patient pathways in London, diverting patients to the relevant specialists within the network. In-line with NICE guidelines and those from the Carter report, working in this collaborative fashion and pooling expertise allows smaller hospitals around the country to divert their pathology as well as patient treatment to larger hospitals where the relevant expertise exists.
As such, Viapath receives samples from around the UK for cancer testing. Our Histopathology Laboratory at St. Thomas’ alone receives around 45,000 samples per year, each will normally undergo more than one test
A multidisciplinary approach to diagnosing cancer means that teams work closely together, ensuring that a definitive diagnosis can be reached in an accurate and timely manner using the latest technologies and practices.
Further information
A more detailed and visual sample pathway through our Special Haematology Laboratory at Guy’s Hospital appeared on our website in a previous edition of our cancer awareness week, together with an overview of our large Haematological Malignancy Diagnostic Centre at King’s College Hospital.
CLICK HERE to see, in pictures, how we process many of the thousands of suspected cancer samples we receive each year.
Haematological Malignancy Diagnostic Centre

